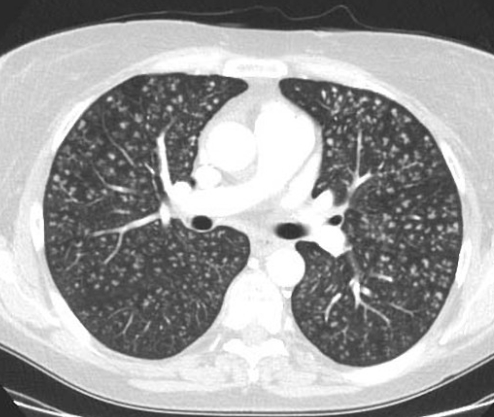
Очаговая диссеминация в легких на КТ

Очаги в легких (что делать врачу, пациенту?) Часть 1
Статья большая, будет опубликована частями, думаю в серию, если вам понравится, конечно - лайки там, комменты, подписки - всё такое.
Тип: научно-популярная статья
Авторы: врач-терапевт, кардиолог Сергей Когай, врач-рентгенолог Павел Жалковский
Год публикации: 2025
С развитием медицины, поступательным движением прогресса в медицинской сфере появляется всё больше различных исследований. И человеку, несвязанному с медициной (а может даже и связанному, просто другой специализации), бывает сложно понять, что же имели в виду врачи, которые взглянули на Вас или пациента изнутри, когда описывали те или иные изменения, обнаруженные при исследованиях.
В этой статье речь пройдёт о термине «очаги в лёгких», так как по данным всемирной паутины, этот термин ставит в тупик большое количество людей, пытающихся понять, что же там увидели врачи-рентгенологи.
«Здравствуйте, можно узнать у Вас, у меня в заключении КТ написали 2-3 мм солидный очаг и мониторинг дообследование, что это означает и страшно ли это?» - к нам поступил такой вопрос. Несомненно, вы не один раз сталкивались с термином «очаг», читая описание рентгенологического исследования. Давайте вместе разберёмся, что же это значит и ответим на вопросы, которые волнуют множество людей, не только пациентов, но и врачей.
Для начала следует сказать, что термин «очаг» может встречаться при визуализации всех внутренних органов человека, вне зависимости от метода исследования. Начиная от рентгенографии органов грудной клетки и заканчивая МРТ головного мозга. Очаг может быть где угодно.
В данной статье разберём что же значат «очаги» применительно конкретно к органам грудной клетки и что с ними делать.
Очаг – локальное уплотнение легочной ткани размером до 1см, окруженное со всех сторон легочной тканью и/или висцеральной плеврой. Термин «очаг» применяется к одиночным или единичным (числом не более 6 в каждом легком) уплотнениям легочной ткани. Множественные очаги, имеющие, как и одиночные, размеры менее 10мм, обычно определяются как легочные (очаговые) диссеминации.
Очаговые изменения в легких, или очаги – термин, который используется в медицине для описания ограниченных участков патологических изменений в легочной ткани, причем очень маленьких, в отличие, например, от пневмонии. В России очагом принято считать локальное уплотнение легочной ткани диаметром до 10мм.
Они могут быть обнаружены при рентгенографии или, чаще, компьютерной томографии, так как она имеет отличное пространственное разрешение, то есть организм, или в нашем случае легкие, можно как бы порезать тоненькими слоями поперек по 1мм. С такой разрешающей способностью неудивительно, что у довольно большого процента людей обнаруживается хотя бы один очаг.
Очаги могут иметь различную природу и быть вызваны множеством причин, от инфекции и воспаления до зарождающейся опухоли или фиброза.
Частота выявления очагов в популяции зависит от ряда факторов:
- возраста – чем старше человек, тем выше вероятность их обнаружения, у людей старше 65 лет частота обнаружения очагов достигает 30-50%;
- курения – у курильщиков очаги выявляются в 2-4 раза чаще, при этом риск, что такой очаг злокачественный также выше;
- географических различий – например, в странах Азии, Африки и Восточной Европы, где высокая распространенность туберкулеза, и частота выявления очагов выше;
- перенесенных заболеваний – например, перенесенная пневмония, в частности COVID-19, может - оставлять после себя очаги.
Большинство очагов в легких имеют доброкачественную природу, задача рентгенолога заподозрить неладное, если ему не понравились те или иные очаги.
Некоторые характеристики очагов помогают врачу предположить, о каком именно процессе идет речь. Но, к сожалению, нельзя со 100% уверенностью при первом же осмотре заявить, что этот очаг точно является тем-то или тем-то. Медицина, как известно, наука вероятностей.
К таким характеристикам относятся:
Размер – от милиарных (в переводе с латинского milium – просяное зернышко, то есть очаги совсем мелкие) до крупных. Причем хоть понятие «милиарные очаги» у людей, так или иначе связанных с медициной, ассоциируется с одноименной формой туберкулеза, при которой в обоих легких обнаруживаются многочисленные мелкие очаги, это не единственное заболевание с такой картиной, а лишь отражение ситуации, что очаги распределились по всем легким и, скорее всего, из кровеносных сосудов с частичками содержимого крови, то есть носят гематогенный характер. И нередко это содержимое - инфекционный или другой воспалительный агент, но также может оказаться и метастазами опухолей. Наличие картины множественных милиарных очагов (или, по-другому, диссеминация) требует дообследования.
2.Количество – одиночные (солитарные), немногочисленные или множественные.
3. Локализация – где расположены, от одного сегмента одного легкого до всех долей обоих легких.
4. Расположение относительно элементов легких
- центрилобулярные - внутри мельчайших легочных структур – вторичных легочных долек (список болезней, проявляющихся такими очагами огромен, от бронхиолита – воспаления бронхиол - структур, которые меньше бронхов, до интерстициальных заболевания – группы болезней, так скажем, самого легочного каркаса);
- перилимфатические - вдоль лимфатических сосудов и плевры, так как по ней также проходят такие сосуды (к такому расположению, например, тяготеют очаги саркоидоза, представляющие сомой гранулемы или, что более грозно, лимфогенный карциноматоз – распространение опухолевых клеток);
- хаотичные – расположенные без четкой привязанности (так часто ведут себя упомянутые в разделе про размер очаги гематогенного распространения).
5. Структура – кальцинированные или нет
Если нет, то по КТ очаг принято относить к одной из трех групп (так решила международная группа ученых под названием Флейшнеровское сообщество)
- солидные – ударение на первый слог, они так называются не потому, что какие-то крупные или вызывающие восхищение по другому поводу, а потому, что в переводе означает «твердые, плотные», то есть сквозь них не видно остальную ткань легкого;
- по типу «матового стекла» - уже не такие плотные, и как будто мы видим мутноватое затуманенное стекло, через которое врачу видно остальную ткань легкого;
- частично солидные – как Вы догадались, такой очаг имеет черты и солидного и по типу «матового стекла».
Если пациент чувствует себя плохо и предъявляет жалобы на органы дыхания или какие-либо другие, то по характеристикам выявленных очагов врач может попытаться предположить, чем именно болеет пациент. Это довольно сложное занятие, ведь дифференциальный ряд огромный, и доктору, зачастую, нужно знать анамнез (то есть как давно и как именно пациент болеет), данные лабораторных анализов и других исследований. И, даже зная все это, доктор скорее всего выскажет лишь свое предположение, с чем же все-таки имеет дело, указывая вероятность.
Продолжение - если вам понравится - не понятно - надо оно такое вам или нет. Или на нашем сайте
Статья целиком (доступна зарегистрированным пользователям, бесплатно, если что)
Источники, использовавшиеся для создания статьи
Словарь терминов в торакальной визуализации (Glossary of Terms for Thoracic Imaging). Тюрин И.Е. (Москва), Авдеев С.Н. (Москва), Гаврилов П.В. (Санкт-Петербург), Вестник рентгенологии и радиологии Рецензируемый научно-практический журнал Том 104, № 5, 2023г.